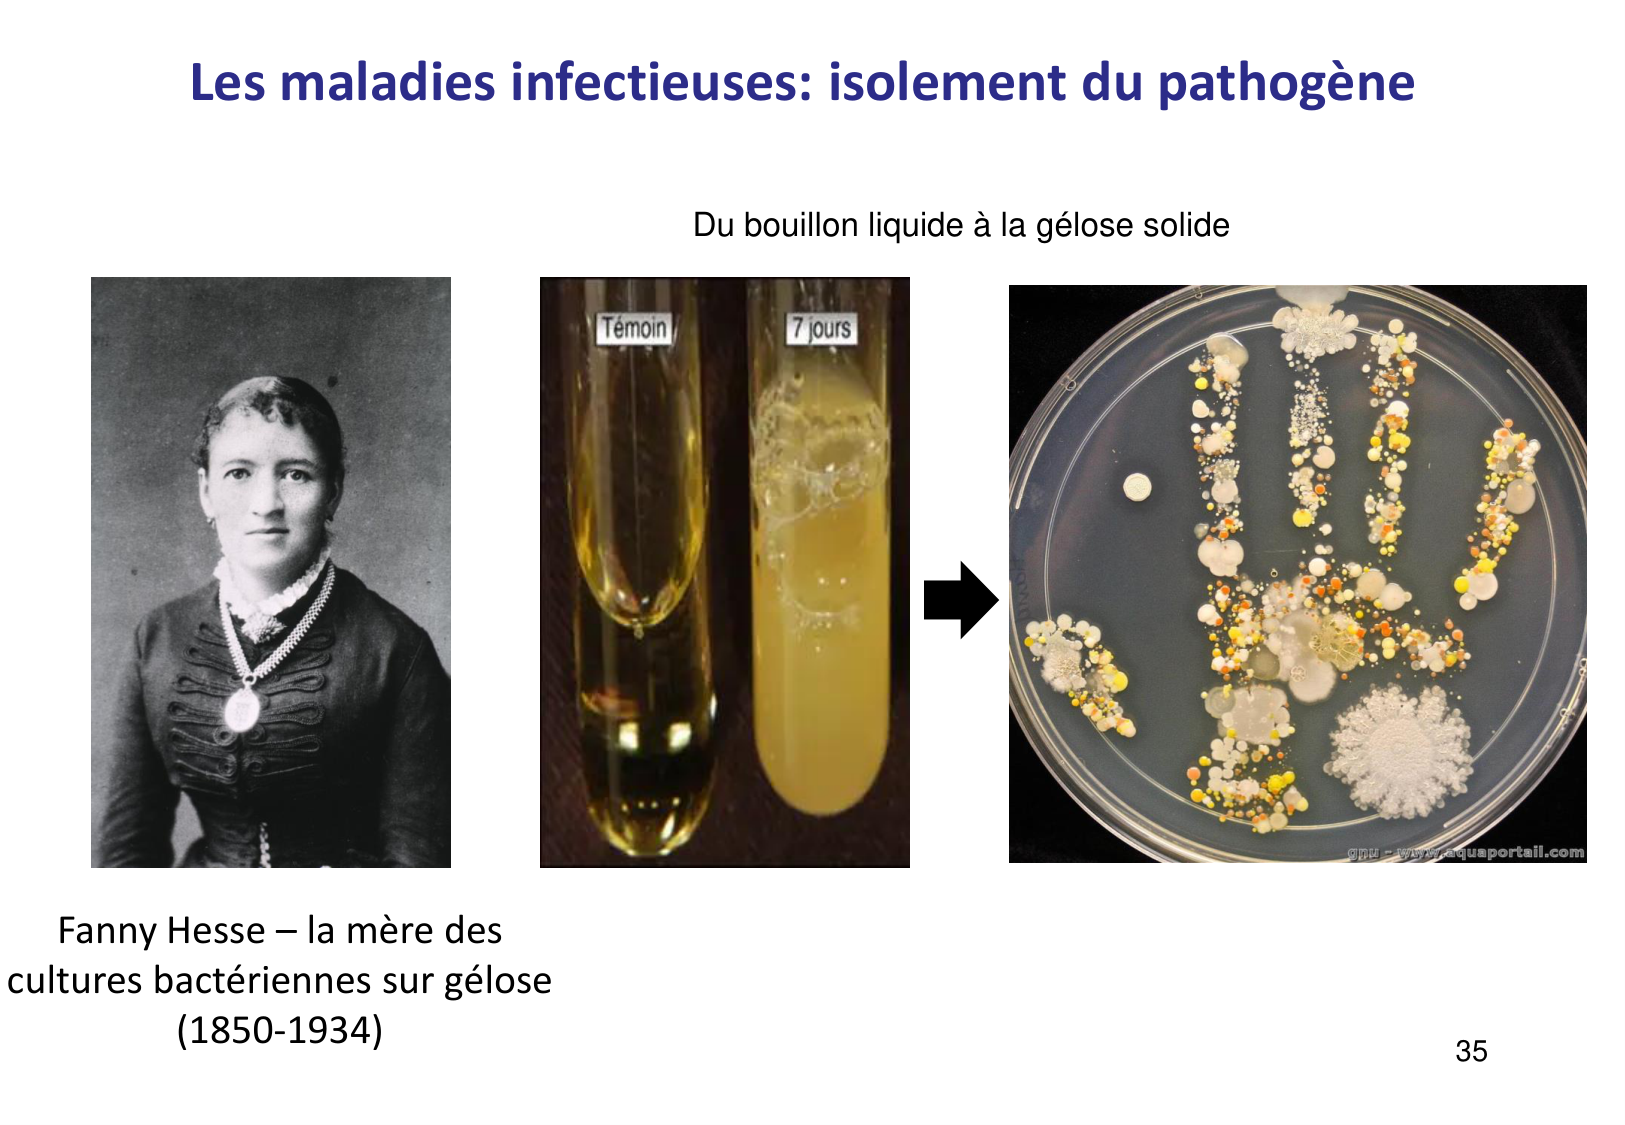
Introduction à la microbiologie — diapositives page 35

07.02 · Page 1

Introduction to microbiology — slides
SMB1 De la molécule à la cellule Introduction à la microbiologie · 65 pages · 9 sections
All pages overview. This static page is crawlable without JavaScript and exposes every page image directly.